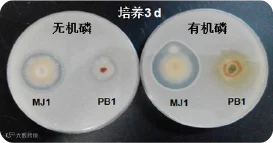

点击
蓝字

关注我们
产品图片
黑
曲
霉

菌种专利号:ZL201610408722.X
传统肥料施入农田土壤中,养分缓慢被物根系吸收利用,而未及时吸收的养分,会与某些离子结合,形成难溶盐,根系难以利用,固定在土壤中,出现肥效短、后劲不足、缺素等问题。同时,原本存在于土壤中的硅、钙、铁、镁等元素,也由于形态原因无法被根系吸收。


百沃生物科技研发生产的黑曲霉菌剂产品,内含的黑曲霉菌在土壤中生长繁殖产生大量有机酸和植酸酶,能够激活土壤固定的磷、钙、镁、锌、硅、铁等元素,将养分转化成作物可以吸收利用的形态,如同一个个微型肥料厂安装在根系周围,不断为植物提供养分。

通过施用黑曲霉菌剂,小麦、玉米、水稻等禾本科作物籽粒饱满,茎秆坚韧抗倒伏;花生、大豆结荚作物空瘪率下降;苹果、葡萄、柑橘、草莓防畸形果、裂果;茄科、葫芦科作物延缓植株衰败,减少畸形果;白菜、芹菜、甘蓝预防烧心、烂心;萝卜、大姜、马铃薯封垄快,表皮光滑。



技术指标:农用微生物菌剂 颗粒 有效活菌数≥2亿/g
包装规格:20kg/袋
用法用量:麦稻玉20-40kg/亩,大田经济作物40-100kg/亩,果树100-150kg/亩,保护地蔬菜100-200kg/亩。

扫描二维码关注公众号
百沃公众号:baiwoshengwu

本文部分图片源自网络,如有侵权,请联系删除!



